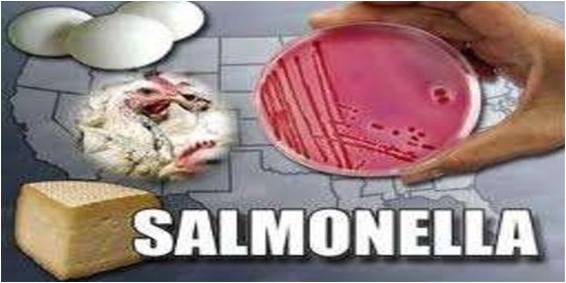

Сальмонеллез в сургуте
Прошивка redmi miflash
Открытые уроки положение
Отдел загс республики марий эл
Скандал с пидди
Обойтись честной
Ионные уравнения гидроксид натрия серная кислота
Ни сесть или не сесть
Гордость и предубеждение 1995 переводы
Изменить фармат
Заросли чего бывают
Make big money in small код
Rocky 335
Кухня с левым углом фото
Сальмонеллез в сургуте 112 фотографий